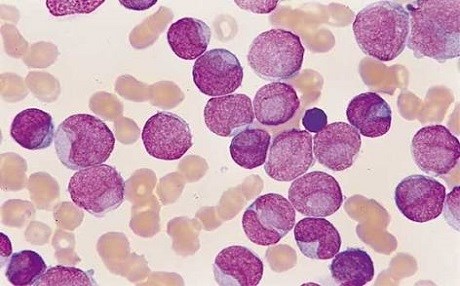

Haber Merkezi- Kanser Araştırmaları Enstitüsü'nden Profesör Greaves, mikroplardan arındırılmış modern yaşam biçiminin çocuklarda en sık görülen kanser türlerinden birine yol açtığını söyledi.
İngiltere'nin önde gelen kanser uzmanlarından Profesör Mel Greaves, 30 yıldır yapılan araştırmalarda görülen kanıtların, yaşamın ilk yıllarında yeterli derecede mikroba maruz kalmazsa, bağışıklık sisteminin kanserojen olabileceğini gösterdiğini belirtti.
Mel Greaves, bu tür kan kanserleri, müreffeh toplumlarda daha sık görülüyor ve bu durum da çağdaş yaşam biçimimizdeki bir unsurun hastalığa yol açıyor olabileceğine işaret etti.
Daha önce hastalığa elektrik kablolarının, elektromanyetik dalgaların ve kimyasalların sebep olabileceği söyleniyordu.
Bu tahminler Prof. Greaves'in Nature Reviews Cancer adlı bilimsel yayında yer alan araştırmasıyla çürütüldü.
Hastalıkta üç aşama bulunduğunu vurgulayan Prof. Greaves, “Birinci aşama durdurulması pek mümkün olmayan anne karnındaki bir genetik mutasyon oluyor. Daha sonra yaşamın ilk yılında çeşitli mikroplara yeterince maruz kalınmaması nedeniyle bağışıklık sistemi tehditlerle doğru şekilde başa çıkmayı öğrenemiyor. Bu hal de çocuklukta karşılaşılan bir enfeksiyonun bağışıklık sisteminin hata vermesine ve lösemiye neden oluyor” dedi.
Bu teori, tek bir araştırmadan elde edilen bir sonuç olmaktan çok, çok sayıda araştırmada yapılan tespitlerin bir yapboz gibi biraraya getirilmesiyle oluşturuldu.
Prof. Greaves, "Bu araştırma, akut limpblastik löseminin net bir biyolojik nedeni olduğunu ve bağışıklık sistemi yeterince gelişmemiş çocukların geçirdiği çeşitli enfeksiyonla tetiklendiğini gösteriyor" dedi.
Greaves'in teorisine dayanak olarak gösterdiği çalışmaların bazılarıysa şöyle:
“Milano'da yedi çocuğun lösemiye yakalanmasına yol açan domuz gribi salgını, kreşe giden ya da daha büyük kardeşleri olan çocuklarda daha çok bakteriye maruz kaldıkları için daha az lösemi görüldüğünü tespit eden araştırmalar, bağırsaktaki iyi bakterileri geliştiren anne sütünün lösemiye karşı koruma sağlaması, normal doğumla dünyaya gelenlere kıyasla bebeğe daha az mikrop geçiren sezaryenle dünyaya gele çocuklarda daha sık görülmesi, mikroplarda arındırılmış ortamda büyütülen hayvanlarda enfeksiyona maruz kalınca lösemi vakalarının ortaya çıkması.”
Prof. Greaves "En önemlisi aslında çoğu vakada löseminin önlenebilir olması" diyor ve çocuklara yoğurt gibi yiyeceklerle bir iyi bakteri kokteyli verilmesini öneriyor.
Greaves ayrıca, anne ve babaların sık görülen önemsiz enfeksiyonlar konusunda daha rahat davranmasını ve diğer, daha büyük çocuklarla sosyal teması özendirmelerini taviye ediyor.
Kan kanserleri alanında çalışan yardım kuruluşu Bloodwise'dan Dr. Alasdair Rankin ise, şu ifadeleri kullandı:
“Anne ve babaların bu çalışmayla paniğe kapılmamalarını istiyoruz. Güçlü bir bağışıklık sistemi riski biraz daha azaltabilir ama şu anda çocukluktaki lösemi vakalarını tamamen önlemek için yapabileceğimiz yöntem yok.” (Kaynak: BBC)

Yorumlar
Misafir olarak yorum yazın ya da daha etkili bir deneyim için oturum açın
Yorum yazın